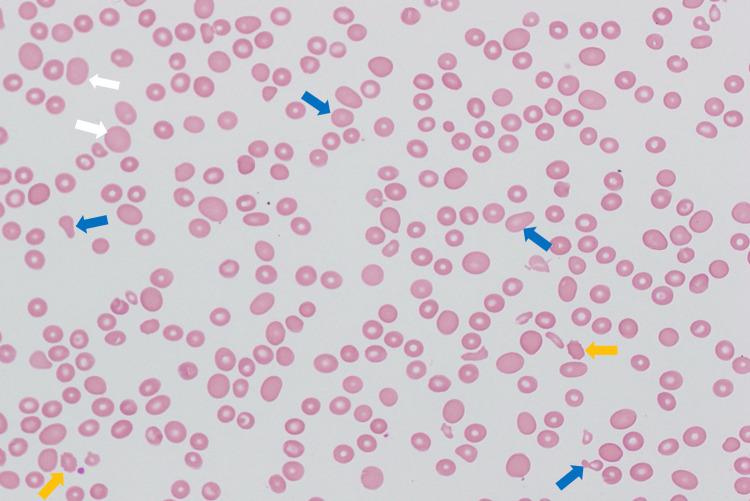
https://cdn.ncbi.nlm.nih.gov/pmc/blobs/5d0f/12349174/2dd0c2454afa/cureus-0017-00000087911-i01.jpg

揭开恶性贫血的面纱:一种由严重维生素B12缺乏引起的全血细胞减少的可逆病因。
Unmasking Pernicious Anemia: A Reversible Cause of Pancytopenia Due to Severe Vitamin B12 Deficiency.
作者信息
Habeb Bola, Khair Sandy, Reid Amber
机构信息
Internal Medicine, Ascension Sacred Heart/Florida State University College of Medicine, Pensacola, USA.
Radiation Oncology, National Cancer Institute, Cairo University, Cairo, EGY.
出版信息
Cureus. 2025 Jul 14;17(7):e87911. doi: 10.7759/cureus.87911. eCollection 2025 Jul.
Vitamin B12 (cobalamin) is a vital cofactor in DNA synthesis and hematopoiesis, and its deficiency can lead to a wide spectrum of clinical manifestations, ranging from asymptomatic macrocytosis to severe hematologic and neurologic complications. While megaloblastic anemia is the most common presentation, prolonged or profound deficiency can result in pancytopenia due to ineffective hematopoiesis and intramedullary cell death. This can mimic more serious bone marrow disorders, including leukemia or aplastic anemia, potentially leading to invasive diagnostic procedures if the deficiency is not promptly recognized. Pernicious anemia is the most common cause of vitamin B12 deficiency in developed countries. It is an autoimmune condition characterized by intrinsic factor deficiency due to antibodies targeting either intrinsic factor itself or gastric parietal cells. It often presents insidiously and is frequently diagnosed late, typically after complications such as pancytopenia or irreversible neurologic damage have developed. Timely identification and treatment with parenteral vitamin B12 can lead to rapid hematologic recovery and prevention of permanent neurologic injury, highlighting the importance of considering pernicious anemia in the differential diagnosis of pancytopenia.
维生素B12(钴胺素)是DNA合成和造血过程中至关重要的辅助因子,其缺乏可导致广泛的临床表现,从无症状大细胞增多到严重的血液学和神经系统并发症。虽然巨幼细胞贫血是最常见的表现,但长期或严重缺乏会因无效造血和髓内细胞死亡导致全血细胞减少。这可能类似于更严重的骨髓疾病,包括白血病或再生障碍性贫血,如果缺乏未能及时识别,可能会导致侵入性诊断程序。在发达国家,恶性贫血是维生素B12缺乏最常见的原因。它是一种自身免疫性疾病,其特征是由于针对内因子本身或胃壁细胞的抗体导致内因子缺乏。它通常隐匿出现,经常在后期才被诊断出来,通常是在出现全血细胞减少或不可逆的神经损伤等并发症之后。及时识别并用肠胃外维生素B12进行治疗可导致血液学迅速恢复并预防永久性神经损伤,这凸显了在全血细胞减少的鉴别诊断中考虑恶性贫血的重要性。